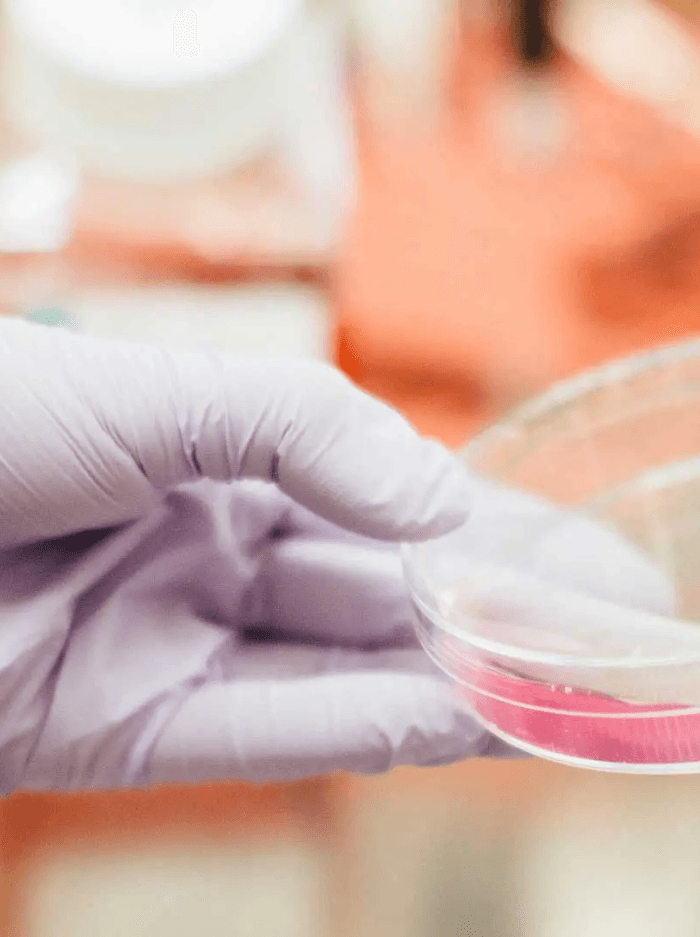

Where Expertise Meets Excellence
Unlocking potential,
maximizing value
Unlocking potential, maximizing value
leveraging geopolitical and macro-economic
tailwinds to deliver superior returns to our investors.
We work diligently to optimize asset values and
constantly monitor data to adjust our strategy as
investment opportunities shift.
– Joe Sitt Chairman & CEO



Where opportunity meets strategy
Welcome to
Thor Equities
With seasoned professionals in five countries, thors investors benefit from hands-on global experience in strategic markets worldwide. Thor has established itself as a trusted partner in the commercial real estate industry and is committed to staying ahead of market trends and exploring innovative strategies to generate sustainable growth for stakeholders.


Assets under
management
Across all sectors from industrial to data centers.
Investments
Including commercial real estate, DTC brands, and more.
Real state square foot pipeline
Across three continents.
Employees globally
With headquarters in the United States, United Kingdom, and Mexico.
Assets under
management
Across all sectors from industrial to data centers.
Investments
Including commercial real estate, DTC brands, and more.
Real state square foot pipeline
Across three continents.
Employees globally
With headquarters in the United States, United Kingdom, and Mexico.
Assets under
management
Across all sectors from industrial to data centers.
Investments
Including commercial real estate, DTC brands, and more.
Real state square foot pipeline
Across three continents.
Employees globally
With headquarters in the United States, United Kingdom, and Mexico.
Subheading
38 year track record
Over the past three decades, Thor Equities has emerged as an industry leader with divisions spread across three continents by experts across all asset classes

Case study
Tudor Portfolio
United Kingdom
Acquired in December 2019 and sold in January 2021, the Tudor Portfolio consists of seven warehouses in London and the Golden Triangle. Thor consistently uses its vast network to identify off-market opportunities and was able to acquire this property at an ideal time and sell it months later at the height of the market.
- 139.5% levered IRR
- 7 high quality assets
- 2.2m square feet

Thor is a trusted partner and advisor to international brands across all industry
Thor is a trusted partner and advisor to international brands across all industry

Case study
Thor Ventures
Presenting a division of Thor Equities focused on venture capital investing in technology and transformative businesses globally.

Madhappy
In 2017, Madhappy launched as a lifestyle brand aiming to create engaging products and experiences that create conversation around mental health. In a space that has been dominated by sentiments of negativity, we set out to spread a sense of optimism and openness among our communities. Madhappy has grown to become a powerful product, content and storytelling platform, reshaping the narrative around what a brand can be.


A deeper dive into our thinking
Thor insights
The Thor team has spearheaded many successful ventures through leveraging its strategic vision and innovative viewpoints.











